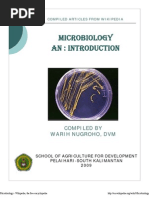
Download general microbiology  by Supriya Sharma SN119621675 doc pdf

- Journal Impact Factor by api-3744715 SN:6774615
- Infectious Disease Epidemiology by mwambungup SN:13697994
- Infectious Diseases in Camelids by Eloisa Zúñiga SN:94063484
- The Effectiveness of Lemon Grass by John Daniel Paulino Gumban SN:102108967
- Viral Latency and Immune Evasion by ማላያላሠማላያላሠSN:31421955
- Foodborne Diseases in Malaysia a Review by ma_e_harun SN:89925331
- Microbiology by Hong Quang Pham SN:39790232
- Airborne Infectious Diseases ASHRAE by Scott Sanders SN:66728027
- MD Consult by ELS-HS SN:6442783
- Emerging Infectious Diseases - Vol. 14 by rvcf SN:50320038
- Text Book of Sarcoidosis with Homeopathy treatment by Dr. Rajneesh Kumar Sharma MD Hom SN:28063978
- Disease Emergence and Resurgence: The Wildlife-Human Connection by MaÃra SN:18224806
- GUIA CLINICA DE ENCEFALITIS 5 by Bachira Nazar SN:49195664
- Anal Sex by efraincantu SN:262191726
- “Nanoantibiotics†- A new paradigm for treating infectious diseases using nanomaterials in the antibiotics resistant era by Chhay Vanna SN:93658439
- general microbiology by Supriya Sharma SN:119621675
- Emerging Infectious Diseases by mani SN:86055227
- Carl Scully - Vaccination Report by Meryl Dorey SN:25951132
- Infectious Diseases by Mayank Vermani SN:64950601
- Top Biological Sciences Journals According to Subjects and ISI Impact Factor 2008 by NTUSubjectRooms SN:57424268
- blastomices dermatiditidis by ariadna_macias SN:44529134
- Journals Consult Feb 2008 by ELS-HS SN:6442646
- Control of Communicable Diseases Manual (1) by Chris Mahfood SN:66449751
- isi-list by wokesh SN:22012366
- Blue Book - Guidelines for the Control of Infectious Disease by avarathunny SN:69422846
- Emerging Infectionus Diseases Sep2012 by Suhail Gattan SN:105199184
- Oral, Genital, Anal, Sex STDs, Infections, Diseases by R Tyler SN:123906800
- argumentative essay 4 vaccines by api-302259647 SN:292986565
- Rot Infecto Residente Medicina Interna Uis. blog 110509 by AgustÃn Vega Vera SN:15225415
- Lyme Disease by jobinbionic SN:7674945
Arsip Blog
-
▼
2019
(4300)
-
▼
February
(1332)
- Lesson Journalism Course Outline
- Examples Learn French Vocabulary With Songs
- Ebook Academic Presentation Outline
- Lists Journalist David Wilson
- Free How To Learn Real Estate Agent
- Lists Manual Can Opener Description
- Collections Learn How To Type Fast On Keyboard Pro...
- Learn Learn Welding Machine
- Lists Learn Simple Farsi
- Learn Youtube Learn Electric Guitar
- Lists Rubbermaid Manual Sweeper
- Lesson Honda Accord V6 Manual 2013
- Collections References For Lesson Plan
- Lists List Of Essay Topics For Upsc
- Learn Online Presentation Tools For High School St...
- Free How To Learn Nepali Rap
- Ebook Example Essay About Family Love
- Lesson Gratitude Journal Books
- Lists Primary Lesson On Gratitude
- Downloads Manual Generator Transfer Switch 100 Amp
- Downloads Learn Binary To Decimal
- Lesson Journal Sentinel Jason Webb
- Lists American Journal Genetics Part A
- Lesson Indicates A Manual Line Break
- Ebook List Ebook Ng Th Cổ đạI HoT
- Free Learn Words Vocabulary
- Learn Four Presentation Methods
- Free Presentation Maker Apk Download
- Examples Journal Clinical Immunology Endocrine Met...
- Downloads Medical Journal Jobs
- Collections Lesson Plan In English Order Of Adject...
- Learn Math Books For Class Xi
- Lists Argumentative Essay Examples College Level
- Lesson Keurig Bolt Manual
- Examples Lesson Plan In Curriculum Evaluation
- Ebook Lesson Plans For School Age
- Lists Audi A6 For Sale Manual Transmission
- Downloads Fort Wayne Journal Gazette Weekender
- Ebook Learn By Heart Multiplication Tables
- Examples Current Medical Journal North Zone
- Examples Diagnostic Essay About Yourself
- Collections Essay Writing College Admission
- Free Typical Presentation Board Sizes
- Ebook Ubd Lesson Plan Example Kindergarten
- Lesson Learn English Online Group
- Ebook 10 Minute Interview Presentation No Powerpoint
- Free Learn Windows 10 Advanced
- Examples Learn Biblical Hebrew Grammar
- Collections Sat Essay Method
- Lesson War Journalism Books
- Collections Lesson Plans For School Age
- Downloads Learned Name
- Free General Journal Format Excel
- Lists Manual De Carreu Nombre Completo
- Ebook Ebook Landing Page Design Templates
- Learn Presentation Layer User Interface
- Collections Lesson Quiz 4-1 Colonial Economy
- Learn Lesson 27 Words From Other Languages Answers
- Free Manual De Gramatica Y Ortografia Para Hispano...
- Learn Learn To Fly Fish Nyc
- Learn Manual Reversible Winch
- Lesson Learn Genetics Asexual Interactive
- Examples Ebooks On The Ipad
- Examples Learn How To Use Microsoft Excel Spreadsheet
- Collections Books By Michael Pollan
- Lesson Manual Wheelchair Brands
- Ebook Learn Tree Farm
- Ebook Journaling Reasons
- Learn Journal About Favorite Movie
- Free Essay Writing Citing Sources
- Lesson Lesson Plan Of Btc 3Rd Semester
- Ebook Lesson Plan For Grade 4 Physical Education
- Examples Podcast Lesson Plan
- Lesson Manual Jeep Patriot 2014
- Lists Analyst Journal Impact Factor 2017
- Downloads Solo Learn Kotlin
- Ebook Different Essay Starters
- Examples Learning Python Buy Online
- Ebook Lesson Plan For Teachers In English
- Learn Learn Bulgarian Phrases
- Free Self Presentation At Job Interview
- Lists Manual Ability Classification System Italiano
- Collections Genie Garage Door Opener Cm8600 Manual
- Free Book Apple Appointment Genius Bar
- Downloads Learn Quickbooks Free.Com
- Lists Learn Dutch From German
- Examples Learn Spanish In Santiago Chile
- Free Learn Latin Now
- Downloads Manual Car Rental Boulder
- Examples Essay Outline Doc
- Learn Oswaal Books For Class 10 Free Download
- Ebook Journal Gazette Mattoon Il Phone Number
- Lists Best Manual Tile Cutter On The Market
- Downloads Pocket Size Ebook Reader
- Downloads Journal Of Vascular Surgery Abbreviation
- Collections Presentation About Video Editor
- Examples Revit Tutorial Rendering
- Ebook Ebooks For General Medicine
- Ebook Reflection Journal On Emotional Intelligence
- Downloads Mitchell News Journal Sports
-
▼
February
(1332)
Powered by Blogger.
Mengenai Saya
Tuesday, February 26, 2019
Lesson Journal Of Infectious Diseases Wiki
Subscribe to:
Post Comments (Atom)
Cari Blog Ini
-
WA6165D Manual Minisplit by Jose Less SN:318097917 Tarjetas Electronicas de Minisplit by Edu...
-
Building PhotoKast: Creating an iPhone app in one month by Ten23 Software SN:12684298 Simula...
-
Descargar Libro Sobredosis Completo PDF Gratis by juan luis SN:323776501 PDF eBooks Textboo...

No comments:
Post a Comment